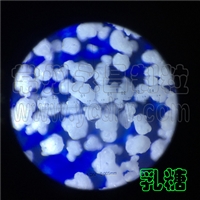
�߲���ȡ�����ܷ��������������-������-������������

实验室闪蒸干燥机发货,湖北融通高科先进材料
旋转闪蒸干燥机,闪蒸干燥机,
对浆糊状、膏糊状、滤饼状的物料连续干燥机
XSG-2实验室闪蒸干燥机(免费提供样机做试验)
国内小型实验室专用闪蒸干燥机,清洗方便,欢迎你带料做试验,免费提供试料。
工作原理
热空气切线进入干燥器底部,在搅拌器带动下形成强有力的旋转风场。膏状物料由螺旋加料器进入干燥器内,在高速旋转搅拌桨的强烈作用下,物料受撞击、磨擦及剪切力的作用下得到分散,块状物料迅速粉碎,与热空气充分接触、受热、干燥。脱水后的干物料随热气流上升,分级环将大颗粒截留,小颗粒从环中心排出干燥器外,由旋风分离器和除尘器回收,未干透或大块物料受离心力作用甩向器壁,重新落到底部被粉碎干燥。
性能特点
◎旋流、流化、喷动及粉碎分级技术的有机结合。
◎设备紧凑,体积小,生产效率高,连续生产,实现了
◎"小设备,大生产"。
◎干燥强度大,能耗低,热效率高。
◎物料停留时间短,成品质量好,可用于热敏性物料干燥。
◎负压或微负压操作,密闭性好,效率高,消除环境污染。
适应物料
有机物:阿特拉津(农药杀虫剂)、月桂酸隔、苯、安息香酸、杀菌丹、
草酸钠、醋酸纤维素、有机颜料等。
染料: 蒽醌、黑色氧化铁、靛蓝颜料、丁酸、氢氧化钛、硫化锌、各种偶
氮染料中间体。
无机物:硼砂、碳酸钙、氢氧化物、硫酸铜、氧化铁、碳酸钡、三氧化锑、
各种金属氢氧化物、各种重金属盐、合成冰晶石等。
食品: 大豆蛋白、胶凝淀粉、酒槽、小麦糖、小麦淀粉等。